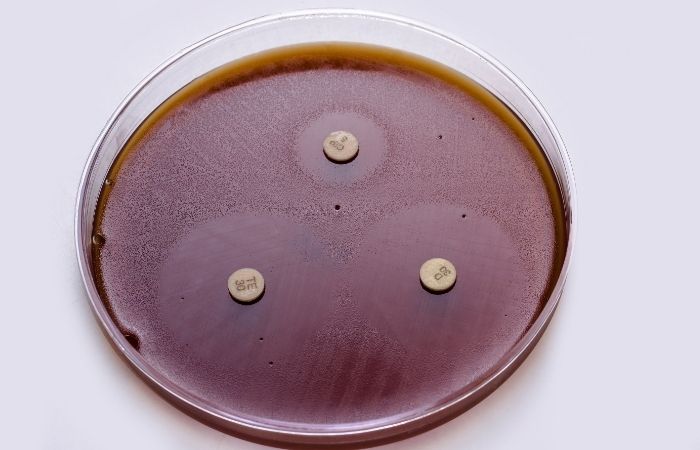

The Growing Demand for Private STD Testing
You’ve probably heard this line before: “Don’t worry, they gave me antibiotics. It’s gone now.”
But here’s the part that gets left out: not all STDs respond to the same treatment. And in 2025, some of the most common antibiotics for STDs, like azithromycin and even ceftriaxone, aren’t doing their job anymore in certain cases.
In other words? The pill you got in 2015 might not work in 2025.
Quick Answer Box
No, one antibiotic doesn’t cure all STDs. Different infections require specific medications, and resistance is rising. Always confirm your diagnosis before taking any treatment.

People are also asking: How do I know if antibiotics are working?
Why Testing Before Treating Is Non-Negotiable
Imagine taking ibuprofen for a broken arm. That’s essentially what you’re doing when you take antibiotics without knowing which STD you have. Here’s what doctors, pharmacists, and sexual health experts agree on:
"You cannot safely or effectively treat an STD without knowing what it is."
And yet, people try it all the time. They rely on old prescriptions. They Google symptoms. They panic and borrow a friend’s leftover meds. But here’s the risk:
- You might be taking the wrong antibiotic for the bacteria
- You might be treating the wrong infection entirely
- You might be taking too little or for too short a time
- You might actually be dealing with a virus (like Herpes or HIV) that antibiotics won’t touch
All of this leads to treatment failure, increased resistance, and worse, thinking you’re cured when you’re still contagious.
That’s why the first step is confirming your infection. You can do that discreetly at home with a Multi-STD Essential Kit or condition-specific tests like the Chlamydia Home Test Kit or Syphilis Test Kit. No clinic visit. No waiting room. No shame.
Check Your STD Status in Minutes
Test at Home with RemediumGenital & Oral Herpes Test Kit

Order Now $75.00 $98.00
For all 2 tests
STD vs. Antibiotic: What Works and What Doesn’t
Here's a comparison chart based on the latest treatment guidelines from the CDC, WHO, and peer-reviewed research:
|
STD |
Recommended Antibiotic(s) |
Cure Rate |
Resistance Risk (2025) |
|
Chlamydia |
Doxycycline (7-day course) |
97–99% |
Low |
|
Azithromycin (single dose – outdated in many regions) |
~88% |
Medium |
|
|
Gonorrhea |
Ceftriaxone (injection) + doxycycline (dual therapy) |
95–98% |
High |
|
Syphilis |
Penicillin G (injection, single or multiple doses) |
98–100% |
Low |
|
Doxycycline (alternative for penicillin allergy) |
80–90% |
Low |
|
|
Trichomoniasis |
Metronidazole or tinidazole (single or 7-day dose) |
95%+ |
Medium |
|
Mycoplasma genitalium |
Moxifloxacin (second-line); azithromycin failing in 40%+ cases |
~85% |
Very High |
|
Herpes (HSV-1/2) |
Not cured by antibiotics, antivirals only |
N/A |
N/A |
|
HIV |
Not cured by antibiotics, requires antiretroviral therapy |
N/A |
N/A |
In short:
- Bacterial STDs = possibly curable with antibiotics
- Viral STDs = not curable with antibiotics
- Some bacteria = now resistant to standard treatments
When STD Antibiotics Fail: It’s Not Always Your Fault
You took the pills. You followed the directions. So why are your symptoms back? Or worse, why didn’t they go away at all? Here’s what might have happened:
- You were prescribed the wrong antibiotic for your infection.
- Your strain was resistant to the drug used.
- You weren’t actually dealing with a bacterial STD in the first place.
- You didn’t take the full dose, or took it irregularly.
- Your partner didn’t get treated, so you got re-infected.
STD antibiotic failures are becoming more common, especially with gonorrhea and mycoplasma genitalium. In fact, some global health agencies now call drug-resistant gonorrhea a “superbug in the making.”
That’s not fearmongering, it’s public health reality. And if you skipped proper testing before taking antibiotics? You might not even know what you were fighting in the first place.
People are also asking: Can I treat gonorrhea with leftover antibiotics?
Real Stories: When Treatment Works (and When It Doesn’t)
Let’s talk about the lived reality. These aren’t hypotheticals. These are real people navigating their sexual health, sometimes with success, and sometimes with setbacks.
Success: Nadia, 29
“I tested positive for chlamydia with a home test. I didn’t want to go to a clinic, so I used the result to request a prescription via telehealth. I took doxycycline for a week, and my symptoms cleared. I retested three weeks later, negative. It worked, but only because I knew exactly what I was treating.”
Failure: Jake, 32
“I had a sore throat and thought it might be an STD after a hookup. I took leftover azithromycin from my roommate thinking it’d cover everything. Two weeks later, I tested positive for gonorrhea in my throat, still positive, because the strain was resistant to azithro. I had to get a shot and go back on doxycycline. Lesson learned.”
Failure: Camila, 25
“I was told I had a UTI. Turns out it was trichomoniasis. I took antibiotics for the wrong thing and spent three extra weeks in pain until I got the right meds, metronidazole, after a home test showed what it actually was.”
What Experts Say: Testing First, Then Treating Correctly
We spoke with Dr. Alicia Roman, a sexual health specialist and researcher on treatment-resistant infections.
“Too often, we see patients who self-treated with the wrong antibiotic. They think they’re being proactive, but really they’re risking resistance. The key is always accurate testing first, and then following proper guidelines. That’s how you treat the person and not just the guess.”
Testing isn't just a formality, it’s a blueprint for treatment. And thanks to at-home options, there's no reason to delay getting clear answers.
Check Your STD Status in Minutes
Test at Home with Remedium7-in-1 STD Test Kit

Order Now $129.00 $343.00
For all 7 tests
The Cost of Getting It Wrong
Here’s what happens when the wrong antibiotic is used:
- The infection lingers, and continues damaging the body
- You stay contagious, and might unknowingly infect others
- Your symptoms may temporarily subside, but return worse
- The bacteria adapts, becoming harder to treat next time
- Your mental health takes a hit, from uncertainty, shame, and stigma
You deserve better than a band-aid solution. You deserve certainty. And that starts with a confirmed diagnosis, not a half-remembered prescription from your college years.
FAQs
1. Can one antibiotic cure all STDs?
No. Different STDs require different medications, and some STDs, like herpes and HIV, aren’t curable with antibiotics at all.
2. What’s the most effective antibiotic for chlamydia?
Doxycycline is currently the gold standard. Azithromycin is less effective due to rising resistance.
3. Why didn’t my STD go away after treatment?
You may have used the wrong antibiotic, had a resistant strain, or got re-infected from an untreated partner.
4. What if I don’t know which STD I have?
Don’t guess, test. Use a Multi-STD Home Test Kit to find out exactly what you’re dealing with.
5. Are there STDs that antibiotics don’t cure?
Yes. Herpes, HPV, and HIV are viruses. They’re managed with antivirals or ART, not antibiotics.
6. Can I get antibiotics without seeing a doctor?
Yes, but only after testing and confirmation, often via telehealth or after a lab result. Some clinics and platforms offer this post-diagnosis.
7. Do at-home STD tests work?
Yes. Trusted brands like STD Rapid Test Kits use certified labs and accurate collection methods. Many tests are FDA-approved or CE-marked.
8. Should I take antibiotics just in case?
No. That can worsen resistance, delay correct treatment, and cause false relief. Only treat after testing.
9. What’s the safest way to handle a potential STD?
Test immediately, abstain from sex during treatment, alert partners, and retest if symptoms linger or you’re unsure.
10. How long after antibiotics should I feel better?
Depends on the STD. Chlamydia symptoms often improve in 2–5 days, but always finish the full course and consider retesting 3 weeks later.
Don’t Treat the Guess, Treat the Truth
The STD you think you have and the one you actually have might be two different things. And even if you get it right, using the wrong med, or using it incorrectly, can make things worse. That’s why the smartest, safest move is to test first, and treat based on facts, not fear.
You're not just treating an infection, you’re protecting your long-term health, your partners, and your peace of mind. Think you need antibiotics? Don’t guess. Start with answers. Use an at-home STD test kit to know what’s really going on, then treat smart, treat safely, and treat with confidence.
Sources
1. 2025 CDC STD Treatment Guidelines
2. Antibiotic Resistance in STDs – WHO





